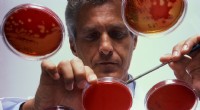
Telling in de microbiologie:nauwkeurige technieken voor het tellen van levensvatbare microben

Wetenschap
Analogie van het endocriene systeem:begrijpen hoe hormonen werken
Dit is waarom:
* Radiostations: Elke endocriene klier is als een radiostation en produceert en geeft hormonen af (de ‘boodschappen’).
* Hormonen (berichten): Deze hormonen fungeren als chemische boodschappers en reizen door de bloedbaan (de 'luchtgolven') om specifieke doelcellen of organen te bereiken.
* Doelcellen/organen (ontvangers): Deze doelcellen of -organen hebben receptoren die specifiek aan de hormonen binden, net zoals radio's die op een specifieke frequentie zijn afgestemd.
* Reactie (uitzending): Wanneer een hormoon zich aan zijn receptor bindt, veroorzaakt het een specifieke reactie in de doelcel of het doelorgaan, zoals een radioprogramma dat op een ontvanger wordt afgespeeld.
Hier zijn enkele andere manieren om erover na te denken:
* Het endocriene systeem is als een postdienst , waarbij hormonen de ‘letters’ zijn en de bloedbaan het ‘bezorgnetwerk’.
* Het endocriene systeem is als een symfonieorkest , waarbij elke klier een ander instrument is en de hormonen de ‘tonen’ zijn die samenwerken om een gecoördineerde reactie te creëren.
Deze analogieën helpen de complexe en onderling verbonden aard van het endocriene systeem te illustreren, waarbij het belang van de productie, het transport en de ontvangst van hormonen voor het in stand houden van de algehele lichaamsfunctie wordt benadrukt.
 Welke elementen vormen natriumhydroxide?
Welke elementen vormen natriumhydroxide?  Chemici melden biohernieuwbaar, biologisch afbreekbaar plastic alternatief
Chemici melden biohernieuwbaar, biologisch afbreekbaar plastic alternatief Een nieuw op polyethyleen-B4C gebaseerd beton voor afscherming
Een nieuw op polyethyleen-B4C gebaseerd beton voor afscherming Zelfvoorzienende lus van chemische reacties kan een revolutie teweegbrengen in de productie van geneesmiddelen
Zelfvoorzienende lus van chemische reacties kan een revolutie teweegbrengen in de productie van geneesmiddelen Wat is de naam als een ionische verbinding die bestaat uit lithiumionen en jodiumionen?
Wat is de naam als een ionische verbinding die bestaat uit lithiumionen en jodiumionen?
 Begrijpen waarom zangvogels hun huis kiezen
Begrijpen waarom zangvogels hun huis kiezen  Waarom is het belangrijk om alle natuurlijke hulpbronnen zorgvuldig te gebruiken?
Waarom is het belangrijk om alle natuurlijke hulpbronnen zorgvuldig te gebruiken?  Welke bodemhorizon bevat de meeste biologische activiteit?
Welke bodemhorizon bevat de meeste biologische activiteit?  Hoe zwarte kevers te identificeren in Noordoost-VS
Hoe zwarte kevers te identificeren in Noordoost-VS  Wisseling van de wacht:onderzoek werpt licht op hoe planten ademen
Wisseling van de wacht:onderzoek werpt licht op hoe planten ademen
Hoofdlijnen
- Waaruit cellen bestaan?
- Evolutie begrijpen:definities en sleutelconcepten
- Wat is de belangrijkste erkenning van codominantie?
- 'Vliegende vaccinator':kunnen genetisch gemanipuleerde muggen een nieuwe strategie tegen malaria bieden?
- Wat is een voorbeeld van eukaryotische plantencel?
- Waar gaat fotosynthese over?
- Waarom vereiste hij celtheorie veel wetenschappelijke bijdragen?
- 10 soorten dierencel?
- Bacteriën die geen aerobe ademhaling vereisen?
- Hoe fotosynthese en cellulaire ademhaling met elkaar verbonden zijn:een dubbele energiecyclus

- Waarom is het zo moeilijk voor soorten om hun ecologische niche te verlaten?

- Telling in de microbiologie:nauwkeurige technieken voor het tellen van levensvatbare microben
- Waarom gedijt dit invasieve, niet-inheemse rietgras in de wetlands?

- Een nieuwe strategie die door Helicobacter pylori wordt gebruikt om mitochondriën aan te pakken

 DNA is een macromolecuul dat informatie opslaat Welk onderdeel van de bron deze informatie?
DNA is een macromolecuul dat informatie opslaat Welk onderdeel van de bron deze informatie?  Wat is het waar aan de valsnelheid van een objecten bij het naderen van het oppervlak?
Wat is het waar aan de valsnelheid van een objecten bij het naderen van het oppervlak?  Kan zonne-energie fossiele brandstoffen ooit volledig vervangen?
Kan zonne-energie fossiele brandstoffen ooit volledig vervangen? Een aardappel in water kweken voor een wetenschappelijk project
Een aardappel in water kweken voor een wetenschappelijk project Wat verliezen we als onze oude buitenwijken verdwijnen?
Wat verliezen we als onze oude buitenwijken verdwijnen?  Hoe kunnen zonnestormen de aarde beïnvloeden?
Hoe kunnen zonnestormen de aarde beïnvloeden?  Het opgooien van munten beïnvloedt de uitkomst van penalty's
Het opgooien van munten beïnvloedt de uitkomst van penalty's Wat was de naam van de Poolse astronoom die bewees dat de aarde rond de zon circuleert?
Wat was de naam van de Poolse astronoom die bewees dat de aarde rond de zon circuleert?
- Elektronica
- Biologie
- Zonsverduistering
- Wiskunde
- French | Italian | Spanish | Portuguese | Swedish | German | Dutch | Danish | Norway |

-
Wetenschap & Ontdekkingen © https://nl.scienceaq.com

